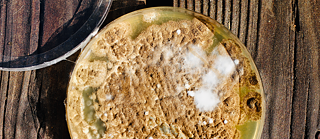

Podcast
Folgen
Produzierende
Wusstet ihr, dass es einen eigenen FEHLER-Podcast gibt? In den Features widmen sich unsere Autor*innen mit viel Herzblut den schönsten Fehlern, Missverständnissen und Irritationen. Hört rein und erfahrt alles über verlorene Radioarchive, das Malen mit Schimmel und den von Fehlern gesäumten Weg der Künstler*innen.
Alle Stücke findet ihr auch auf Spotify und Apple Podcasts. Radiosender können die Folgen in sendefähiger Qualität bei PRX herunterladen.
Sylvia Cunningham
ist stellvertretende Redakteurin bei KCRW Berlin 104.1 FM, wo sie Studio Berlin comoderiert und die monatliche Storytelling-Show The Bear on KCRW Berlin produziert. Sie zog 2017 von New York nach Berlin und arbeitet seitdem für KCRW Berlin.Sylvias Beitrag: Schlimme Fehler sorgen für gute Geschichten
Katie Davis
ist Autorin und Radioproduzentin aus Washington, D.C. Sie arbeitet für All Things Considered (NPR) und This American Life. Für ihr aktuelles Projekt „Anacostia Unmapped“ hat sie Bewohner*innen des Washingtoner Viertels Anacostia dabei unterstützt, Radioporträts über ihre Nachbar*innen zu produzieren.
Katies Beitrag: Versuch macht klug
Melissa Gerr
ist Autorin für Audio, Video und Print. Derzeit produziert und verfasst sie Beiträge für die Radiosendung On the Record von WYPR, dem Partner von National Public Radio in Baltimore, Maryland.Melissas Beitrag: Wenn das Schicksal Regenbögen freisetzt
Bilal Qureshi
ist Radiojournalist und Autor mit Schwerpunkt Kultur. Seine Essays und Kritiken sind in der New York Times und der Washington Post erschienen. Er verfasst Radiobeiträge und Podcasts für NPR, etwa für die Sendungen „Code Switch“ und „Pop Culture Happy Hour“.Bilals Beitrag: Die Kunst der Fehler: falsch schreiben
Jocelyn Robinson
ist Pädagogin und freie Medienproduzentin aus Ohio. Jocelyn engagiert sich stark für die Erhaltung des lokalen Rundfunks und arbeitet auch bei der African American And Civil Rights Radio Caucus Of The Radio Preservation Task Force, ein Projekt der Library Of Congress.Jocelyns Beiträge: Die vergessenen Bänder von WYSO, Sorry, ich hab‘ mich verwählt!
Flawn Williams
hat viele Jahre für das National Public Radio (NPR) gearbeitet und an der Georgetown University Audiojournalismus und Aufnahmetechnik unterrichtet. Er war technischer Leiter der Podcast-Reihe The Big Pond des Goethe-Instituts und lebt in Maryland.Flawns Beitrag: Als der Weltuntergang irrtümlich vor der Tür stand
Verónica Zaragovia
zog im Rahmen eines Stipendiums der Robert‑Bosch‑Stiftung 2016 aus den USA nach Deutschland. Seitdem lebt sie zumeist in Berlin. Als Stipendiatin des Pulitzer Centers erzählt Verónica multimediale Geschichten aus aller Welt – auch aus ihrem Geburtsland Kolumbien.Verónicas Beitrag: Die zufällige Entwicklung von Kunststoff